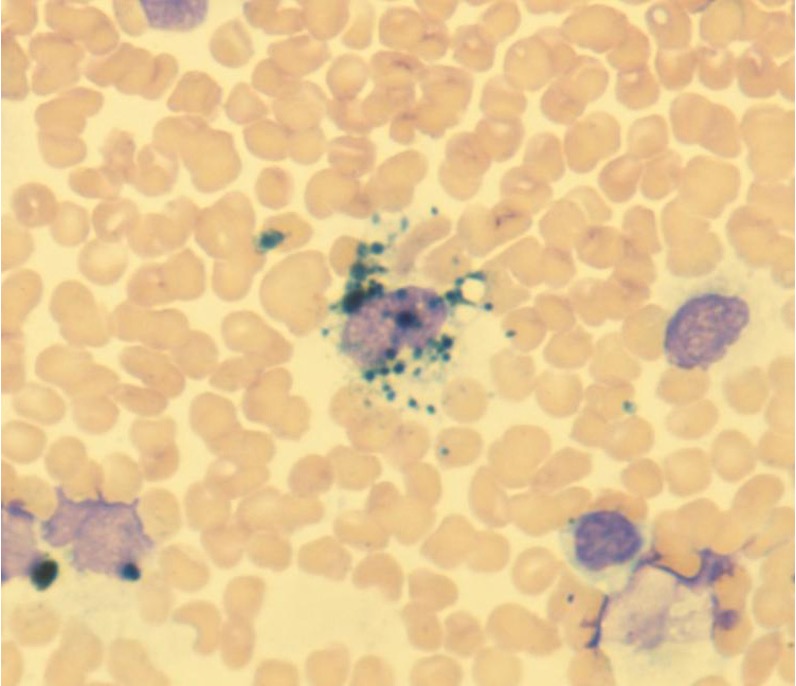
James Noake tweet media

Lucy Allen
7K posts

Lucy Allen
@LCphysio
MCGI. Strategy Manager. NHS. Leadership. Physiotherapist. Views are my own.

Are you a UK-based physiotherapist working in a MSK setting? Please support this Masters research into MSK pain and menopause. Your insights are crucial! Please take part here: bit.ly/42spMCg @NicGriffin2 Please feel free to share. @UH_PG_Physio @PhysioMACP @UH_HSK

Change is changing & the Project, Programme or Portfolio Management Office (PMO) needs to change as well. Many articles about the future of PMOs stress the impact of AI & automation on the PMO role. That's going to make uniquely human skills for PMOs even more important. In the past, the PMO was often largely focussed on control: timelines, RAG ratings, risks. The PMO of the future: 1) will move beyond delivery reporting - it will reflect on direction 2) won’t just track outputs - it will amplify outcomes 3) won’t just ask, “Are you on track?” — it will ask, “Where’s the energy? What are we learning? And how can we help?” 4) will focus less on delivery hygiene & invest more in human connection, so that the whole system can move forward. A picture of the momentum-building PMO of the future from @noelito: noelito.medium.com/from-pmo-to-le….








